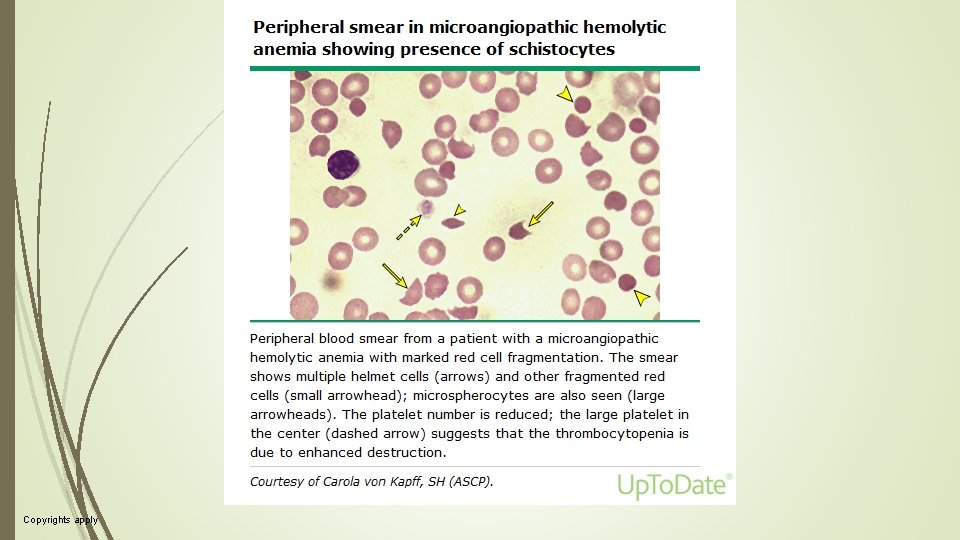
Copyrights apply Copyrights apply

Hemolitik Anemiler Do Dr Yldz Okuturlar 11 12

- Slides: 82
Hemolitik Anemiler Doç. Dr. Yıldız Okuturlar 11. 12. 2018
Hemolitik anemi, Dolaşımdaki eritrositlerin (RBC) erken yıkımları kısalmış yaşam süreleri ile ortaya çıkan bir durum Kalıtsal ve edinilmiş Akut ve kronik Hafif veya potansiyel olarak yaşamı tehdit eden şiddette
Demir eksikliği veya kanama olmamasına rağmen hastada retikülosit sayısında artış vardır. Hastalarda ayrıca Artmış laktat dehidrojenaz (LDH) Artmış bilirubin Azalmış haptoglobin Periferik kan yaymada RBC şekli değişiklikleri RBC yıkımı olduğuna dair kanıtlar
Hemolitik Anemiler Sıcak OİHA Paroksismal soğuk hemoglobinüri Soğuk aglitünin hastalığı Hemoglobinopatiler İlaç ilişkili HA RBC membran defektleri RBC enzimatik defektler MAHA (TTP, HUS, DITMA) Kan Tx İlişkili HA PNH
RBC Yaşam Döngüsü Bir kırmızı kan hücresinin (RBC) tipik ömrü yaklaşık 110 ila 120 gündür (dört ay). Bu süre zarfında, RBC'ler, çaplarından çok daha küçük olan kılcal damarlar ve dar kordonlarda hareket ettiklerinden, önemli ölçüde mekanik gerilime maruz kalırlar Bu tekrarlanan dolaşımdaki devir, RBC ömrü boyunca milyonlarca kez olur.
RBC'nin bu gerilime dayanmasına izin veren özellikleri arasında, Yüksek oranda deforme olabilen bir membran Hücre iskeleti, Optimal yüzey-hacim oranı Hücrenin uygun redoks ortamını sürekli olarak geri getiren bir enzimatik sistem bulunmaktadır.
RBC'lerin normal yaşlanması, yaşa bağlı RBC yıkımı ile sonuçlanır. Bu tipik olarak günlük RBC'lerin yaklaşık olarak % 1 oranında gerçekleşir. Dolaşımdan temizlenen RBC'lerin yüzdesi, hemolitik durumlarda dramatik olarak artabilir
Hemoliz, eritrositlerin dolaşım ve retiküloendotelyal sistem yoluyla geçişler sırasında sağlam yapısını koruyamadığında ortaya çıkar. Herhangi bir mekanizma ile hemoliz, böbrek tarafından artmış eritropoietin (EPO) salgılanması ile RBC üretiminde kompansatuvar bir artışı uyarır. EPO, daha fazla RBC öncüsü üretmek için kemik iliğini uyarır; bu, birkaç gün içinde retikülosit sayısında bir artış ve hemoglobin seviyesi ve hematokritte bir artış ile biriki gün içinde izlenir.
Anemi oluşumu ve ciddiyeti, hemoliz derecesi ile kemik iliğinin RBC üretimini artırma kapasitesi arasındaki denge ile belirlenir. Retikülosit ömrü (RLS) ve retikülosit yüzdesi önemlidir. RLS, hematokrit azaldıkça orantısal olarak artar. Çünkü dolaşıma daha erken fazda katılırlar. Anemi olmadığı zamanlar RLS yaklaşık bir gündür. Şiddetli anemide, retikülositler 1. 5 gün hatta 2, 5 gün önceden dolaşıma salınır.
Kavramsal Sınıflamalar İntrakorpüsküler defekt (intrensek) daha çok kalıtımsal nedenler Extrakorpüsküler defekt (ekstrensek) Kalıtımsal Kazanılmış Akut hemoliz Kronik hemoliz İmmün mekanizmalar İmmün olmayan nedenler İntravasküler Ekstravasküler (KC ve dalakta retiküloendotelyal makrofajlar) daha çok immün nedenler
Hemoliz sınıflamaları İntrakorpüsküler Extrakorpüsküler Defekt eritrositin kendisinde Başka nedenler (enfeksiyon, ilaç) Hb yapı ve fonksiyonu Dış etkenlere bağlı Membran yapı ve fonksiyonu Erken membran kaybı Stoplazmadaki metabolik mekanizmalar Memranda yapısal hasar RBC volüm kontrolü Hb solübilitesinde değişiklik Volüm kaybı veya artışı Selüler protein değişiklikleri
İntrakorpüsküler hemoliz Hemoglobinopatiler Rbc Membran/sitoskeletal defektler Orak hücreli anemi Herediter sferositozis Talasemi Herediter eliptositozis Unstabl Hb varyantları Herediter stomatositozis Hb solübilitesi bozulur ve membran hasarı Membran yüzey alanı ve volüm oranında bozukluk Bazı anormal Hb ler Heinz cisimcikleri
İntrakorpüsküler hemoliz Membran metabolik anormallikleri İntrakorpüsküler G 6 -Fosfat dehidrogenaz eksikliği Hepsi kalıtsaldır Prüvat kinaz eksikliği Kalıtsal kusurlar intrakorpüskülerdir Metabolik kapasite bozulur Solit transport ve oksidan hasardan iyileşme bozulur PNH istisnadır ve kazanılmış intrakorpüsküler defekt vardır. Kompleman lizisine hassas klon varlığı Herediter TTP kalıtsal extrakorpüsküler defekt vardır ve mikrovasküler mikroanjiopatik hemoliz vardır
Ekstrakorpüsküler hemoliz Mekanik nedenler İmmünolojik Enfeksiyonlar Metabolik/oksidan hasarlar Genellikle kazanılmıştır
Ekstrakorpüsküler hemoliz Hipersplenizm Mekanik travma Staz Yüksek hıza bağlı travma Yakalama Protez kapaklar Destrüksiyon şeklinde olur Fonksiyonu bozuk kapaklar DIC Sıcak antikorla kaplı RBC TTP İntrakorpüsküler defektli RBC HÜS DITMA
Ekstrakorpüsküler hemoliz Oksidan bileşiklere maruziyet Patojenlerin destrüksiyonu Anilin boyaları, dapson, fenazopiridin Malarya Özellikle altta yatan defect varsa Babesiosis G 6 PD eksikliği Bartonellosis Konjenital methemoglobinemi Klostridyum perfiringes Anstabil Hb varyantları (sulfonamid) Yılan ve böcek ısırıkları Belirli toksinler Termal yanıklar Bakır zehirlenmesi (Wilson Hastalığı)
İmmün olan nedenler İmmün hemoliz genellikle RBC yüzeyine bağlanan antikorlar ve / veya kompleman proteinler tarafından RBC yıkımıdır. İmmün hemoliz pozitif direkt antiglobulin testi (DAT; direkt Coombs testi olarak da adlandırılır) ve / veya pozitif indirekt antiglobulin testi (indirekt Coombs testi) ile karakterizedir. İmmün aracılı hemolizin yaygın nedenleri arasında AIHA, ilaca bağlı hemoliz ve hemolitik transfüzyon reaksiyonları yer alır. Bağışıklık hemolizinin daha az görülen nedenleri arasında paroksismal soğuk hemoglobinüri ve soğuk aglutinin hastalığı yer alır.
Copyrights apply
Copyrights apply
RBC yıkım yeri - Hemoliz yeri intravasküler (dolaşım içinde) veya ekstravasküler olabilir (retiküloendotelyal makrofajlar ve karaciğer dalak, kemik iliği ve lenf nodlarının monositleri aracılığıyla). Hemoliz bölgesi, belirli tanı testlerinin sonuçlarını etkiler ve sıklıkla hastanın klinik şiddetini ve acil yönetim ihtiyaçlarını belirler. Bu durum, serbest hemoglobin gibi RBC yıkımı ürünlerinin retiküloendotelyal sisteme veya dolaşıma salınmasını belirler. Hemoliz ürünleri dolaşıma serbest bırakılırsa, serbest serum hemoglobin veya idrar hemoglobin ve hem, veya hemosiderin ve hem olarak görünecektir. Serum ve idrar pembe veya koyu kahverengi olabilir. Dolaşımdaki serbest hemoglobin veya hem, böbrekte ciddi hasara neden olarak, akut böbrek yetmezliğine neden olabilir ve DIC'yi tetikleyebilir veya tromboz riskini artırabilir
AIHA'daki RBC yıkımı genellikle ekstravaskülerdir, çünkü retiküloendotelyal makrofajlar progresif olarak otoantikorlarla kaplı olan küçük RBC membran parçalarını fagositize eder. Buna karşılık, mekanik travmadaki (örneğin, prostetik kalp kapağı, , marching, bongo drums) hemolizde, eritrosit, retiküloendotelyal sisteme ulaşmadan önce, dolaşım içinde olabilir. Benzer şekilde, komplemanın membran atak kompleksinin (MAC) RBC zarında bir delik oluşturduğu durumlarda (örn. , Paroksismal noktürnal hemoglobinüri [PNH], paroksismal soğuk hemoglobinürisi [PCH]), büyük bir intravasküler hemoliz ortaya çıkar. Bununla birlikte, birçok durumda, özellikle hemoliz şiddetli olduğunda, hem intravasküler hem de ekstravasküler hemolizi vardır.
İntravasküler hemoliz RBC memranında ciddi yapısal hasar olduğunda (örn. , Mekanik hasar, kompleman MAC) veya retiküloendotelyal sistem kapasitesini aştığında ortaya çıkar. İntravasküler hemoliz ciddi düzeyde olduğunda, serbest serum ve idrar hemoglobinli nedeniyle pembe veya kahverengi serum ve koyu idrar ortaya çıkar. Pembe renk oksihemoglobine bağlıdır ve kahverengimsi renk ise okside form methemoglobine bağlıdır. Serbest hemoglobin haptoglobine bağlanır ve hemoglobin-haptoglobin kompleksi karaciğer tarafından hızlı bir şekilde atılır ve bu da çoğu zaman saptanamayan seviyelere kadar plazma haptoglobininde bir azalmaya yol açar.
Haptoglobin ile bağlanmayan alfa-beta globin dimerleri glomerulus tarafından filtrelenecek kadar küçüktür (moleküler ağırlık 34, 000 dalton) ve idrarda hemoglobinüri olarak görünür. İdrar hemosiderini, böbrek tübüler hücrelerin hemi alması, degrade etmesi, hemosiderin olarak depolaması ve nihayetinde idrarın içine dökülmesi gibi bir intravasküler hemoliz epizodundan birkaç gün sonra görülebilir. İdrar hemosiderinin idrar çökeltisinin Prusya mavisi boyaması (demir boyası) kullanılarak saptanır.
İntravasküler hemoliz nedenleri Bongo drummers ve marş hemoglobinürisinde olduğu gibi doğrudan travma (koşucu veya ayak çarpması hemolizisi) Defektif mekanik kalp valflerinde olduğu membran hasarı Termal yanıklarda olduğu gibi ısı hasarı Paroksismal soğuk hemoglobinüride olduğu gibi komplemanın indüklediği lizis Hipotonik çözeltilerin infüzyonunu takiben ozmotik lizis Bakteriyel toksinlerden (örn. , Clostridial sepsis) lizis Yüksek konsantrasyonlu bakır konsantrasyonlarına maruz kalma ile lizis TTP, HUS veya ilaca bağlı TMA dahil Trombotik mikroanjiyopatiler (TMA) Akut hemolitik transfüzyon reaksiyonu Rho (D) immün globülinin, bağışıklık trombositopeni (ITP) tedavisinde olduğu gibi Rh (D) -pozitif bireylere uygulanması retiküloendotelyal sistemde ağır immün hemoliz
Ekstravasküler hemoliz Ekstravasküler hemoliz, esas olarak karaciğer, dalak, kemik iliği ve lenf nodlarında retiküloendotelyal sistemin makrofajları yoluyla ortaya çıkan hemolizdir. Ciddi derecede zarar görmüş RBC'ler, özellikle komplemanlar ile kaplanmış olanlar, esas olarak, dalaktan daha büyük bir oranda kardiyak output alan bir organ olan karaciğerde tahrip edilir. Sferoitler veya orak hücreler gibi kötü şekilde deforme olmuş RBC'ler öncelikle Billroth kordonlarında dalakta tahrip olur. Hasarlı RBC'ler kordlarda kalır ve monositler ve makrofajlar tarafından fagosite edilir.
Dalakta yok edilen eritrositler genellikle bütün olarak fagosite edilir ve makrofajların fagozomları içinde sindirilir. Her bir hem molekülü, mikrozomal heme oksijenazın etkisi ile eşit mol miktarlarında biliverdin, demir ve karbon monoksite dönüşür. Biliverdin, biliverdin redüktaz enzimi tarafından konjuge olmayan bilirubine indirgenir ve plazmaya bırakılır. Demir, demir export protein ferroportin ile makrofajlardan plazmaya salınmaktadır. Kemik iliğine nakledilir ve yeni eritrositlerin üretiminde kullanılır. Kronik hastalık / inflamasyon anemisi olan hastalarda, demir serbestleşmesi hepcidin etkisine bağlı olarak bozulmakta ve yeni RBC üretimi için demir mobilizasyonunun bozulmasına neden olmaktadır. Karbon monoksit başlangıçta karboksihemoglobin olarak sağlam RBC'lerin hemoglobinine bağlanır. Daha sonra pulmoner kapillerlerde salınır ve süresi dolan ekpire atılır.
Hemolitik aneminin başlıca nedenleri şunlardır: ● Trombotik trombositopenik purpura (TTP) veya hemolitik üremik sendrom (HUS) gibi trombotik mikroanjiyopati (TMA) ● Orak hücre hastalığı ● Akut hemolitik transfüzyon reaksiyonu (AHTR) ● Aort darlığı veya prostetik kalp kapakçığından gelen mekanik hemoliz ● Dissemine intravasküler koagülasyon (DIC) ● Kararsız hemoglobin ● Clostridial sepsis ● Yürütme veya bongo davulundan gelen mekanik hemoliz ● RBC paraziti (örneğin, sıtma, Babesia) ● Hipotonik infüzyondan ozmotik lizis ● İlaç kaynaklı immün hemoliz ● Yılan ısırığı ● Glukoz-6 -fosfat dehidrojenaz (G 6 PD) eksikliği ile ilişkili ilaç kaynaklı hemoliz ● Paroksismal nokturnal hemoglobinüri (PNH) ● İlaç kaynaklı trombotik mikroanjiyopati (DITMA) ● Otoimmün hemolitik anemi (AIHA) ● G 6 PD eksikliği ● Piruvat kinaz (PK) eksikliği ● Beta talasemi ● Alfa talasemi ● Paroksismal soğuk hemoglobinüri (PCH) ● Gecikmeli hemolitik transfüzyon reaksiyonu (DHTR) ● Herediter sferositoz (HS) ● Kalıtsal eliptositoz (HE) ● Kalıtsal stomatositoz (HSt) ● Herediter kserositoz (HX)
TANISAL YAKLAŞIM Klasik prezentasyon Kronik veya yeni başlangıçlı anemi semptomları (örneğin, yorgunluk, halsizlik, nefes darlığı), düşük hemoglobin düzeyi artmış retikülosit sayısı Aktif kanama; demir, vitamin B 12, folat veya bakır replasmanı eritropoietinin uygulanması olmamalıdır
Bazı hastalarda hemoliz tanısından önce hayat kurtarıcı müdahaleler gerekebilir Derin anemide transfüzyon Muhtemel TTP için plazmaferez Akut transfüzyon reaksiyonu için diürez ve bol hidrasyon Hemolitik anemi tanısı yüksek olasılıkla kesinleştiğinde nedeni belirleme ve acil müdahale yaklaşımı şöyle olmalı Hemolizin potansiyel nedenini hedefleyen doğru hikaye ve fizik muayene sağlanması Trombotik mikroanjiyopatiler (TMA), yaygın damar içi pıhtılaşma (DIC) veya bir akut transfüzyon reaksiyonu gibi bireyleri hızla tanımlayın ve tedaviyi başlayın
Eğer hastanın uzun süreli anemisi var ya da klasik herediter hemolitik anemi PY bulguları) varsa, olası durum için spesifik testler yapılmalıdır hemoglobinopati, metabolik defekt membran defektine bağlı kalıtsal hemolitik anemi İmmün nedenler için direct antiglobulin testi (DAT) yapılmalı (Direkt Coombs) Direkt coombs pozitif ise immün hemolitik anemidir DAT negatifse hikaye ve FM bulgularına göre spesifik tanısal testler yapılmalıdır Hemolize yönelik diğer laboratuvar testler
Hemoliz, altta yatan sistemik bir bozukluğun ilk belirtisi olabilir ve ölümü veya hastalıkla ilişkili komplikasyonları önlemek için acil müdahale gerektirebilir. Trombotik trombositopenik purpura, Sistemik lupus eritematozus, Kronik lenfositik lösemi
Hikaye FM Kanamanın yokluğunda anemi semptomlarının hızlı başlangıcı ciddi hemoliz işareti Sarılık, bilirubinin depo demire dönüştürmek için retiküloendotelyal sistemin kapasitesini aşan ciddi hemoliz ile tutarlıdır. Koyu idrar intravasküler hemoliz ile tutarlıdır. Yeni verilen kan transfüzyonu, olası akut hemolitik transfüzyon reaksiyonunu göstermektedir; Geçtiğimiz dört haftadaki transfüzyon da gecikmiş hemolitik transfüzyon reaksiyonunu arttırır. Hemoliz oluşturma potansiyeline sahip yeni bir ilacın başlatılması, ilaca bağlı etyolojinin olası olduğunu göstermektedir.
Aile üyelerinde hemolitik aneminin ya da açıklanamayan aneminin geçmişi kalıtsal bir bozukluğu göstermektedir; Birden çok birinci dereceden aile üyesi etkilenirse bu daha olasıdır. Pigmentli safra taşlarının ya da safra taşlarının varlığı retiküloendotelyal sistemi aşan kronik hemolizi ifade eder. Splenomegali retiküloendotelyal kapasitenin aşöası sonucu gelişir. Kronik kompanse hemolitik anemide bu bulgular ortaya çıkmayabilir
Hemolizi destekleyen laboratuvar bulguları Tek bir spesifik tanı testi yoktur Birden fazla bulgu olması önemlidir Açıklanamayan anemi varlığında RBC üretimindeki artışa sekonder retikülosit artış nedenlerinin olmayışı Yakın zamanda kanama hikayesi Demir replasmanı Vit B 12, folat veya bakır replasmanı EPO uygulanması RBC yıkım belirtileri Artmış LDH düzeyi Düşük haptoglobin Artmış konjüge bilirubin
Hemolitik anemi için spesifik testler Periferik yaymada şistositler veya sferositler; serbest hemoglobin veya pembe serum; pozitif direkt antiglobulin [Coombs] testi [DAT]; anormal hemoglobin gösteren hemoglobin analizi Yüksek oranda destekleyici ve bazı durumlarda var ise tanı koyulur, ancak yokluğu hemoliz olasılığını dışlamaz.
Periferik Yayma Çoğu hemolitik anemi tipinde, diğer kan hücresi sayımları (WBC ve trombosit sayısı) normaldir. Anormal derecede yüksek veya düşük bir WBC, enfeksiyon veya hematolojik maligniteyi önerir Sepsis, direkt RBC lizisine (örn. , Klostridial sepsis, sıtma, barlosellosis veya babesiosis) veya DIC'ye bağlı hemoliz ile ilişkili olabilir. Hemoliz ile klasik olarak ilişkili olan hematolojik maligniteler arasında otoimmün hemolizli kronik lenfositik lösemi (KLL) ve DIC'li akut promiyelositik lösemi (APL) yer alır.
Periferik Yayma Çoğu hemolitik anemi vakasında, retikülositler normal RBC'lerden daha büyük olduğundan, bir miktar makrositoz olacaktır Örnekler arasında Trombotik trombositopenik purpura (TTP) veya ilaca bağlı TMA (DITMA) gibi trombotik mikroanjiyopatiler (TMA'lar); Sıtma veya Babesia gibi enfeksiyonlar; Heinz cisimleri veya ısırık hücreleri, glikoz-6 -fosfat dehidrojenaz (G 6 PD) eksikliği olan bir hastada oksidan bir ilaca bağlı hemolizi gösterir.
Yüksek retikülosit sayısı Yüksek retikülosit sayımı kemik iliğinde RBC'lerin hızlandırılmış bir üretimini ifade eder. Artan retikülositler hemolitik anemide tipik bir bulgudur ancak hemoliz için spesifik değildir; Kemik iliği ayrıca kanamaya, besin replasmanına (örn. , vitamin B 12, folik asit, demir) veya eritropoietin uygulamasına yanıt olarak RBC üretimini artırabilir. Retikülositozun olmaması, bazı bireylerin kemik iliği supresyonu veya retikülosit üretimine engel olan kemik iliği fonksiyonuna eşlik ettiğinden, hemoliz olasılığını ortadan kaldırmaz retikülositler olgunlaşmış RBC'lerden daha büyük olduğundan, merkezi solukluğa sahip olmadığından ve mavimsi bir renk tonuna sahip olduğundan (polikromazisi) periferik kan yaymasından tahmin edilebilir. Birçok sayaç otomatik olarak retikülosit sayısını verebilir
Copyrights apply
Copyrights apply
Retikülositler, RBC'lerin bir yüzdesi olarak veya mutlak bir sayı olarak ifade edilebilir; Bu sayılar anemi derecesi ve dolaşımdaki retikülositlerin ömrü için düzeltilebilir. Bununla birlikte, düzeltmeler sayımı daha doğru hale getirmektedir ve bazı durumlarda retikülositozun gerçekten artmış olup olmadığını belirlemek önemlidir:
Retikülosit yüzdesi tüm RBC'lerin yüzdesidir Total RBC sayımına göre, ciddi anemilerde yapay olarak artmış olabilir ve hasta anemik değilse yapay olarak azaltılabilir. Hemolizsiz bir hastada normal retikülosit yüzdesi yüzde 1 ila 2 arasındadır. Hemoliz ve başka bir şekilde sağlam kemik iliği olan hastalarda, retikülosit yüzdesi en az yüzde 4 ila 5 ve genellikle daha fazladır.
Düzeltilmiş retikülosit sayımı Retikülosit yüzdesi nispi bir sayıdır. Herhangi bir sayıda retikülosit için, toplam RBC sayısı (payda) düşükse, retikülosit yüzdesini artar Bu nedenle, retikülosit yüzdesi, hastanın hematokriti ile, normal bir hematokrit (örn. , Yüzde 45) ile bölünerek, düzeltilmiş bir retikülosit yüzdesi verilebilir. Örnek olarak, yüzde 22. 5 oranında hematokriti olan bir hastada retikülositler yüzde 10 ise, düzeltilmiş sayım aşağıdaki gibi hesaplanabilir: 10 x (22. 5 ÷ 45) = 10 x 0. 5 = 5
Mutlak retikülosit sayımı Mutlak retikülosit sayımı, anemi derecesine bakılmaksızın retikülositoz derecesini doğru bir şekilde yansıtma avantajına sahiptir. Normal mutlak retikülosit sayısı 25. 000 ila 75. 000 / mikro. L arasındadır (yani, mutlak bir RBC sayısının 5. 000 hücre / mikro. L'nin yaklaşık% 1'i). örnek, yüzde 18'lik bir hematokrit, 2. 000 / mikro. L'lik bir RBC sayısı ve yüzde 3'lük retikülosit sayısı olan ciddi anemi hastasıdır. Yüzde 3 retikülosit sayısı yüksek görünürken, mutlak retikülosit sayısı normal aralıkta olan sadece 60. 000 / mikro. L'dir (yani, 2, 000'in% 3'ü).
Düzeltilmiş mutlak retikülosit sayısı -Anemi ne kadar şiddetli olursa, daha genç retikülositler dolaşıma salınırlar ve dolayısıyla dolaşımdaki yaşam süreleri uzar. Mutlak retikülosit sayısı, retikülosit olgunlaşma süresi (RMT) olarak da adlandırılan retikülosit ömrü (RLS) için düzeltilebilir. RLS, sırasıyla 45, 35, 25 ve 15 hematokritlerde 1. 0, 1. 5, 2. 0 veya 2. 5 gündür. Hematokrit% 18 ve mutlak retikülosit sayısı 60. 000 / mikro. L olan bir hastada, RLS yaklaşık 2, 5 gündür; Bu nedenle, düzeltilmiş mutlak retikülosit sayısı (60, 000 ÷ 2. 5 = 24, 000 / micro. L) olup, uygunsuz olarak düşüktür.
Copyrights apply
Retikülosit üretim indeksi (RPI) RPI hematokrit hem de retikülosit ömrü için düzeltmeler yapar (calculator ): RPI = Reticulocytes (percent) x (HCT ÷ 45) x (1 ÷ RMT) Hemoliz veya kan kaybı olmayan bir kişide RPI yaklaşık 1'dir. 2'den 3'e kadar olan bir değer arttığını düşünürken, anemisi olan bir hastada <2 değeri uygunsuz olarak kabul edilir. Bizim hastamız için düzeltilmiş ret 105/1, 5=70 bin RPI= 2, 53 x(37, 5/45)x(1/1, 5)=1, 25 calc 1, 4
Yüksek LDH ve bilirubin; düşük haptoglobin Hemolitik anemide retikülositozdan başka önemli bir diğer tipik bulgu, yıkım ürünlerindeki artış RBC yıkımının kanıtıdır. Hemoliz, RBC'lerden laktat dehidrogenaz (LDH) ve hemoglobin salgılar. Hemoglobin, dolaşımda haptoglobine bağlanır ve böylece hem siklüsüne katılır Hemoglobin degradasyon ve hem siklusunun bir parçası olarak bilirubine dönüştürülür. Böylece, yüksek LDH ve bilirubin ve düşük haptoglobin hepsi hemoliz ile uyumludur. Ancak, birkaç uyarı var: ● LDH ve bilirubin - Bu anormalliklerin başka olası nedenleri olduğundan, yüksek LDH ve bilirubin hemoliz için çok spesifik değildir. Bilirubin yükselmesi hemolizden kaynaklandığı zaman, yükselme ağırlıklı olarak indirekt (konjuge olmayan) bilirubinde bulunur.
Copyrights apply
Copyrights apply
Copyrights apply
Haptoglobin Serum haptoglobin için normal aralık geniş. Düşük bir haptoglobin muhtemelen hemolizden kaynaklanır ve saptanamayan bir haptoglobin seviyesi hemen her zaman hemolizden kaynaklanır. Bir haptoglobin ≤ 25 mg /d. L'nin duyarlılığı ve özgüllüğü yüzde 83 ve yüzde 96'dır. Bununla birlikte, normal veya artmış bir haptoglobin, hemoliz olasılığını ortadan kaldırmaz, çünkü haptoglobin, inflamasyon ortamında arttırılabilen bir akut faz reaktanıdır. Düşük haptoglobin nedenleri arasında abdominal travma ve konjenital ahaptoglobinemi sayılabilir Bu tanı aşamaları acil durum gerektiren müdahaleleri geciktirmemelidir.
Hemoglobin düşüş oranı Hastayı doğru şekilde yönetmek için hemoglobin seviyesinde düşüş oranının bilinmesi önemlidir. Hemoglobinde çok yavaş bir düşüş gösteren bireyler, uç organ iskemisi olmaksızın şiddetli anemiye uyum sağlayabilir ve tolere edebilirken, Mutlak hemoglobin seviyesi çok düşük olmasa bile hemoliz seviyesi ve hemoglobin seviyesinde hızlı bir düşüş yaşayanlar, oldukça semptomatik olabilir ve daha agresif tedavi ve hızlandırılmış değerlendirme gerektirebilir. Düşme oranı, klinik duruma göre belirlenen sıklıkta, hemoglobin düzeyleri, hematokritler ve retikülosit sayımları yapılarak değerlendirilir.
Transfüzyon Şiddetli anemisi olan hastalar, RBC transfüzyonu gerekir özellikle aktif kanama, organ iskemisi semptomları veya devam eden tempolu hemoliz varsa, RBC'lerle transfekte edilmelidir. Daha sonra analiz için depolanabilen, özellikle de hemolitik aneminin kalıtsal bir nedeninden şüpheleniliyorsa, transfüzyon öncesi acil durum aknı vermek (0 Rh -) uygun olabilir. İmmün aracılı hemoliz varlığında cross-match uyumlu kan bulmak zorlaşır. En uygun olanı verilmelidir.
Plazma değişimi Trombotik mikroanjiyopati (TMA; yani mikroanjiopatik hemolitik anemi ve trombositopeni) olgularında tanı testleri birkaç saat sürebilir.
Hidrasyon ve hemodinamik destek Görünürde ciddi intravasküler hemoliz (ABO'ya uyumsuz transfüzyon nedeniyle akut hemolitik transfüzyon reaksiyonu [AHTR]) olan bireyler için dolaşımdaki serbest hemoglobin böbrek yetmezliğine, hipotansiyona ve dissemine intravasküler hidrasyona neden olabilir. Agresif hidrasyon ve diğer destekleyici önlemler önemlidir.
Akut hemolitik transfüzyon reaksiyonu (AHTR) şüphesi halinde agresif hidrasyon tedavisine başlanmalıdır. Hastaya yanlış kan transfüzyonu Yan ağrısı Ciddi hipotansiyon Oligüri / anüri Dolaşımdaki serbest hemoglobinin komplikasyonlarını en aza indirmek için agresif hidrasyon önemlidir Akut böbrek hasarı Dissemine intravasküler koagülasyon Vazospazm semptomları (örneğin, göğüs ağrısı). Normal salin ile hidrasyon, > 1 m. L / kg / saat renal çıkışını korumak için kullanılmalıdır; furosemid gibi intravenöz bir diüretik sıklıkla kullanılır Hemoliz kanıtları ortadan kalkana kadar agresif hidrasyona devam edilmelidir DIC'den şüpheleniliyorsa, kanama derecesi ve laboratuvar bulgularına bağlı olarak trombositler, plazma ve / veya kriyopresipitat dahil olmak üzere ek kan bileşeni transfüzyonu gerekli olabilir.
AHTR için laboratuvar testleri ABO uyumluluk testini tekrarla ABO uyumsuzluğu dışlandığında ek antikor çalışmaları İndirekt antiglobulin (IAT) yöntemi kullanılarak transfüzyon öncesi ve sonrası örnekler ile crossmatch i tekrarlayın Direkt antiglobulin (Coombs) testi (DAT) Pembe renk için serumun gözlemlenmesi ve serbest hemoglobin analizi Hemolizi belgelemek için serum haptoglobin, laktat dehidrojenaz (LDH) ve konjuge olmayan bilirubin seviyeleri Hastada kanama varsa, protrombin zamanı (PT), aktive parsiyel tromboplastin zamanı (a. PTT), fibrinojen seviyesi ve D-dimer dahil olmak üzere DIC için koagülasyon testi Pembe renk için idrarın gözlenmesi ve serbest hemoglobin analizi Hemolitik aneminin şiddetini ve ek RBC transfüzyonunun ihtiyacını belirlemek için seri hemoglobin düzeyleri
Anafilaksi Görünür anafilaktik reaksiyonu olan bir hasta (örn. , Hipotansiyon, hışıltılı, anjiyoödem) subkutan veya intramüsküler olarak epinefrin (1: 1000 solüsyondan 0. 2 ila 0. 5 m. L) almalıdır. Ağır vakalarda, 0, 5 m. L 1: 10, 000 aköz solüsyon intravenöz olarak uygulanabilir. İntravenöz sıvılar (salin) ve bir H 1 -antihistamin (örneğin, kaşıntı veya ödem için oral olarak 10 mg gibi loratadin veya setirizin) de uygulanır. İnhale bronkodilatörler, sürekli pozitif havayolu basıncı (CPAP) ve bir H 2 -antihistamin (örn. Ranitidin) gibi diğer tedaviler, ciddi bronkospazmı olan bazı hastalarda uygun olabilir. Bir anafilaktik reaksiyon için laboratuar testi, Ig. A eksikliği olan bireylerde düşük olacak (kantitatif <7 mg / d. L) kantitatif immünoglobulin A (Ig. A) düzeylerinin yanı sıra immünoglobulin A'ya (anti. Ig. A) karşı antikorların bulunmasını içermelidir.
Hemoliz nedenini belirlemek için yapılan testler Hemolitik aneminin klasik prezentasyonunda, doğrudan spesifik tanı testine devam etmek anlamlı olabilir anemi ve trombositopeni ile gelen ve periferik yaymada çok sayıda şistosit valığı TTP, HUS veya ilaca bağlı TMA gibi bir TMA'yı kuvvetle ön plana çıkarır Bir kan transfüzyonu sonrası ateş, sırt ağrısı, koyu idrar ve pembe plazmanın varlığı AHTR nu düşündürür Hayat boyu anemi, splenomegali ve RBC morfolojisi, sferositler, eliptositler veya stomatoitler gibi kalıtsal hastalıklardan birinin tipik bir örneğidir. Hastalığın yüksek prevalansı olan bir popülasyondaki bir hastada orak hücre hastalığının veya talaseminin kan yayma özelliği. Glukoz-6 -fosfat dehidrojenaz (G 6 PD) eksikliği olan bireylerde hemoliz olduğu bilinen bir ilaca maruz kaldıktan sonra hemoglobin seviyesinde hızlı düşüş.
Copyrights apply
Copyrights apply
Copyrights apply
Copyrights apply
Copyrights apply
Copyrights apply
Copyrights apply
Copyrights apply
Diğer durumlarda, hemolizin nedeni daha az açık olabilir. Örnek olarak, sayısız sferositlerin varlığı, otoimmün hemolitik anemi veya kalıtsal sferositozu gösterebilir. Bu bireyler için, antiglobulin (Coombs) testini (DAT) kullanabiliriz. DAT negatif olanlar için hasta ve aile öyküsüne göre yönlendirilmiş laboratuvar testleri gerçekleştiriyoruz; fiziksel inceleme; hemoliz hızı ve şiddeti; ve RBC morfolojisi. Tanı olasılıklarını daraltmada yararlı olabilecek diğer özellikler arasında şunlar bulunur: • AHTR • Aşırı bakteri enfeksiyonu (örn. , Clostridium perfringens) • Paroksismal nokturnal hemoglobinüri (PNH) • Paroksismal soğuk hemoglobinüri (PCH) Normal plazma rengi olan bir hastada kırmızı ila kahverengi idrar, geçici hemolizden (eğer numuneler eş zamanlı olarak değerlendirilmemişse) veya intravasküler hemolizden başka bir nedenden dolayı olabilir (örn. , Miyoglobinüri, pancar yutma). Splenomegali, konjenital, enfeksiyöz veya neoplastik bir süreçtir.
Tanı olasılıklarını daraltmada yararlı olabilecek diğer özellikler arasında şunlar bulunur: İntravasküler hemoliz (örneğin, pembe serum, pozitif serum serbest hemoglobin, dipstick ile idrarda pozitif hem, idrarda pozitif hemosiderin), aşağıdakilerden birini gösterir: AHTR Ağır bakteriyel enfeksiyon (örn. , Clostridium perfringens) Paroksismal nokturnal hemoglobinüri (PNH) Paroksismal soğuk hemoglobinüri (PCH) Normal plazma rengi olan bir hastada kırmızı ila kahverengi idrar, geçici hemolizden (eğer numuneler eş zamanlı olarak değerlendirilmemişse) veya intravasküler hemolizden başka bir nedenden dolayı olabilir (örn. , Miyoglobinüri, pancar yutulması). Splenomegali konjenital, enfeksiyöz veya neoplastik Kan yaymada anormal bulgu: Sferositler , mikrosferositler ve eliptositler , DAT pozitif ise AIHA'yı düşündürür; Kalıtsal sferositoz içinse azalan Eosin-5 -Maleimid (EMA) Binding, artan ozmotik kırılganlık ve / veya genetik testler önemli Elliptositoz myelodisplaziyi düşündürebilir ve kromozom analizi ile kemik iliği değerlendirmesi önerilebilir Parçalanmış RBC'ler (şistositler, kask hücreleri), mekanik hemolizi veya TMA'yı önerir. • Akantositler (düzensiz hücreler) ve hedef hücreler karaciğer hastalığına işaret eder. Blister veya "ısırık" hücreleri (resim 12) G 6 PD eksikliğinin ayarında oksidan hasar olduğunu düşündürmektedir. Kırmızı hücreli "hayaletler", çoğu zaman baskın bakteriyel enfeksiyonla (örn. , Clostridium perfringens) ilişkili ciddi intravasküler hemolizi gösterir.
Copyrights apply
crystal violet boyama ile Copyrights apply
Copyrights apply
ATİPİK PREZENTASYON • Retikülositoz olmadan Hemoliz Anemi genellikle multifaktöriyeldir ve normal retikülosit yanıtını görmemizi engelleyen eş zamanlı bozukluklar hemolitik aneminin tanısını zorlaştırabilir Bazen anemi maskelenebilir Diğer olgularda, artmış retikülosit sayısının aslında artmış eritropoezin bir göstergesi olabilir. Hemolitik anemi, uygun bir retikülosit cevabı olmadan olabilir ve bu durum daha derin bir anemi ile sonuçlanır Bu tablo, kemik iliği anemiye uygun şekilde cevap veremediğinde ortaya çıkar. Hemolizden emin olunmasına rağmen retikülosit sayısı uygun olmayan şekilde düşükse, retikülosit yanıtının olmamasından sorumlu olabilecek olası birkaç durum vardır: Demir eksikliği (mutlak veya fonksiyonel) B 12 vitamini, folat veya bakır eksikliği Kronik inflamasyon anemisi (kronik hastalık anemisi) Alkol Miyelodisplazi, aplastik anemi veya diğer birincil kemik iliği bozukluğu Eritropoetik öncü hücreleri hedef alan parvovirüs enfeksiyonuna bağlı geçici RBC aplazisi Kronik lenfositik lösemi (KLL) tedavisi gibi ilaç kaynaklı kemik iliği baskılanması
ATİPİK PREZENTASYON Anemi olmadan hemoliz Hemolizden kaynaklanan aneminin üstesinden gelmek için kemik iliği kapasitesinin RBC üretimini artırması yeterli ise, anemisiz hemoliz görülebilir. Normal bir hemoglobin ve hematokrit rağmen, hemoliz bulguları tespit edilebilir Yüksek retikülositoz Artmış serum LDH düzeyi Düşük serum haptoglobin Anemi olmayan hastalarda retikülosit oranının ≤%5 olduğu görülür Hemoliz olmadan retikülositoz Artmış retikülosit sayısına bağlı olarak hemolitik anemiye sahip olduğu düşünülen bir hastanın aslında başka bir retikülositoz nedeni olabilir. Klinik tablo hemolitik anemi ile tam olarak uyumlu değilse veya spesifik bir hemoliz nedeni belirlenemiyorsa, hastanın aşağıdaki gibi retikülositozun başka nedenleri için değerlendirilmesi uygun olabilir: Bir kanamadan geçmiş olma veya devam eden kanama ● Yetersiz olan bir hastada demir, vitamin B 12 veya folatın replasmanı ● Eritropoietinin uygulanması. ● Bir enfeksiyon (örn. Parvovirus), ilaç veya alkol gibi bir kemik iliği baskısından kurtulma.
TROMBOTİK KOMPLİKASYONLAR Hemolitik anemi ve tromboz arasında iyi bilinen bir ilişki vardır, bunlar intravasküler veya ekstravasküler hemoliz ile görülebilir. Mekanizma (mekanizmalar) iyi anlaşılmamıştır Otoimmün hemolizli bazı hastalarda serbest plazma heme veya hemoglobin, nitrik oksit (NO), splenektomi, antifosfolipid antikorlarının tükenmesi ve etkilenen RBC'lerin yüzeyindeki protrombotik değişiklikler ● Paroksismal nokturnal hemoglobinüri (PNH) ● Orak hücre hastalığı (SCD) ● Otoimmün hemolitik anemi (AIHA) ● Herediter sferositoz (HS)
Teşekkürler…